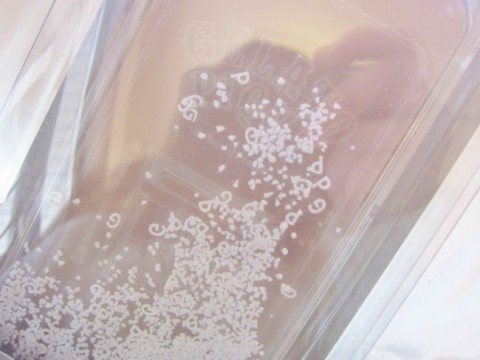
画像

2015年11月21日(土) 13:27
ジェラピケがいっぱい~!!!
店内がクリスマスになったLUCYです★☆
ギフトではもちろん、
ジェラート・ピケ♥
先ほどまたまた大量入荷♪
クリスマス限定アイテムが増えました!
まるでお姫様のチュールに
キラキラの星がきらめいています♥
ディズニー映画に出てきそうな
素敵すぎるドレスです♪
クリスマス限定早くも売れています!
ぜひぜひお早めに☆
他にもいろいろな新作がたっぷり!
今回のコレクションらしいアイテム☆
まさにレディシックな一枚です♪
大人らしさとかわいらしさが詰まってます★
ショートパンツバージョンもあります~!
流行のタートルをお家でも♪
とてもおしゃれで首元はあったか♡
ぎゅ~としたくなるような
ふわもこの着心地も最高です★
ふんわりチュールが素敵なドレス★
カップ付きでうれしい!
上にカーディガンをはおるか、
もこもこプルオーバーをかぶるか
迷っちゃいます♡
わたしも密かにきになっていた
アイフォンケースも入荷しました★
なんとスノードームになってる!
こんなの初めて見ました♡♡
またまたジェラピケコーナー
かわいいがいっぱいです♪
ご自分へのプレゼントにもおすすめです♡
コメント欄はユーザー登録者のみに公開されています
2008-02-11から2,799,260hit(今日:125/昨日:196)